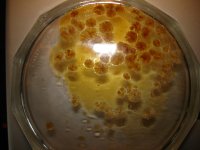
DSC00354.JPG

Update...7/17/2023
Swim trys again ... using only electric E MESH HEAT.. wattage raised from 65 watts...to 68.. watts and found it cleanly vaped over 2 thirds of the product in bowl on first hit! :thumb_up:
WOW!..using an electric E MESH mod..swim got very thick convection vapor!.nothing burnt!.. it worked super!... just by adding 3 watts to the vaporizer...
Everyone may not experiance the same performance as swim did.. ...it all depends on how much outside air is getting into your bowl...if your getting too much air into the bowl...you have to try different wattages...its trial and error untill you find the right air/heat/combo...
Again..[using ..crystals/oil/or wax]..... if you can ..seal out.. all extra outside air.. from entering the bowl...and just get air from the tiny air holes built in to mod top cap....its posible to get great convection vapor at a MUCH LOWER wattage...probibly around 35 to 40 watts...
But..Because a fair amount of extra air was still getting into the vape mixture.... Swim countered this problem by raising the wattage untill the sweet spot was found.....
this time swim was really impressed by the ..tastless..super thick... potent...convection vapor!:thumb_up:
7/18/2023...
Swim suspected these temps might too high?...but suprisingly swim found At 70 and 72 watts... every trace of product! vaporized in the bowl! ...[produced high speed convection vapor!]...and produced a superior buzz..it brought on the light of day!
NOTHING BURNT!!!:thumb_up:
so.. adjusting the temperature even higher...[to a point]... high speed application of hot air only.. convection can perform as well as ... high speed conduction...and much much cleaner without burning or waste..:thumb_up:
using ..[the glass beaker style water pipe in photos above]...and Turning up the wattage ...[ up to 72 watts] .. was quite!! effective!
dont believe Swim needs to go any hotter!
please Note ...that most portable convection vaporizers ...on the market today...are in fact hybrid!!, with only a few exceptions. That's because ... true convection ...requires transferring hot air through the chamber, and only a few portable vaporizers will not directly heat up the chamber to speed up the process.Jun 1, 2023
I find these short films ...symbolic.... much like dreams!
Daisy Belle...full screen.. DUST.
...
Swim trys again ... using only electric E MESH HEAT.. wattage raised from 65 watts...to 68.. watts and found it cleanly vaped over 2 thirds of the product in bowl on first hit! :thumb_up:
WOW!..using an electric E MESH mod..swim got very thick convection vapor!.nothing burnt!.. it worked super!... just by adding 3 watts to the vaporizer...
Everyone may not experiance the same performance as swim did.. ...it all depends on how much outside air is getting into your bowl...if your getting too much air into the bowl...you have to try different wattages...its trial and error untill you find the right air/heat/combo...
Again..[using ..crystals/oil/or wax]..... if you can ..seal out.. all extra outside air.. from entering the bowl...and just get air from the tiny air holes built in to mod top cap....its posible to get great convection vapor at a MUCH LOWER wattage...probibly around 35 to 40 watts...
But..Because a fair amount of extra air was still getting into the vape mixture.... Swim countered this problem by raising the wattage untill the sweet spot was found.....
this time swim was really impressed by the ..tastless..super thick... potent...convection vapor!:thumb_up:
7/18/2023...
Swim suspected these temps might too high?...but suprisingly swim found At 70 and 72 watts... every trace of product! vaporized in the bowl! ...[produced high speed convection vapor!]...and produced a superior buzz..it brought on the light of day!
NOTHING BURNT!!!:thumb_up:
so.. adjusting the temperature even higher...[to a point]... high speed application of hot air only.. convection can perform as well as ... high speed conduction...and much much cleaner without burning or waste..:thumb_up:
using ..[the glass beaker style water pipe in photos above]...and Turning up the wattage ...[ up to 72 watts] .. was quite!! effective!
dont believe Swim needs to go any hotter!
please Note ...that most portable convection vaporizers ...on the market today...are in fact hybrid!!, with only a few exceptions. That's because ... true convection ...requires transferring hot air through the chamber, and only a few portable vaporizers will not directly heat up the chamber to speed up the process.Jun 1, 2023
I find these short films ...symbolic.... much like dreams!
Daisy Belle...full screen.. DUST.

....now after vaping them with the ceramic disc ..they seemed VERY PURE!:shock:
....now after vaping them with the ceramic disc ..they seemed VERY PURE!:shock: 














